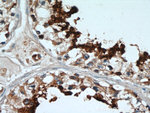
GLIPR1L1 Antibody in Immunohistochemistry (Paraffin) (IHC (P))
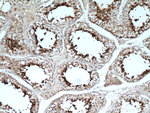
GLIPR1L1 Antibody in Immunohistochemistry (Paraffin) (IHC (P))

Search
Proteintech
GLIPR1L1 Polyclonal Antibody
{{$productOrderCtrl.translations['antibody.pdp.commerceCard.promotion.promotions']}}
{{$productOrderCtrl.translations['antibody.pdp.commerceCard.promotion.viewpromo']}}
{{$productOrderCtrl.translations['antibody.pdp.commerceCard.promotion.promocode']}}: {{promo.promoCode}} {{promo.promoTitle}} {{promo.promoDescription}}. {{$productOrderCtrl.translations['antibody.pdp.commerceCard.promotion.learnmore']}}
产品信息
20828-1-AP
种属反应
宿主/亚型
分类
类型
抗原
偶联物
形式
浓度
规格
纯化类型
保存液
内含物
保存条件
运输条件
产品详细信息
Immunogen sequence: SKIPSITDP HFIDNCIEAH NEWRGKVNPP AADMKYMIWD KGLAKMAKAW ANQCKFEHND CLDKSYKCYA AFEYVGENIW LGGIKSFTPR HAITAWYNET QFYDFDSLSC SRVCGHYTQL VWANSFYVGC AVAMCPNLGG ASTAIFVCNY GPAGNFANMP PYVRGESCSL CSKEEKCVKN LCKNPFLKPT GRAPQQTAFN PFSLGFLLLR IF (23-233 aa encoded by BC014603)
靶标信息
Plays a role in the binding between sperm and oocytes. Component of epididymosomes, one type of membranous microvesicules which mediate the transfer of lipids and proteins to spermatozoa plasma membrane during epididymal maturation. Also component of the CD9-positive microvesicules found in the cauda region. [UniProt]
仅用于科研。不用于诊断过程。未经明确授权不得转售。
篇参考文献 (0)
生物信息学
蛋白别名: GLI pathogenesis related 1 like 1; GLIPR1-like protein 1
基因别名: ALKN2972; GLIPR1L1; PRO7434; UNQ2972/PRO7434
UniProt ID: (Human) Q6UWM5
Entrez Gene ID: (Human) 256710